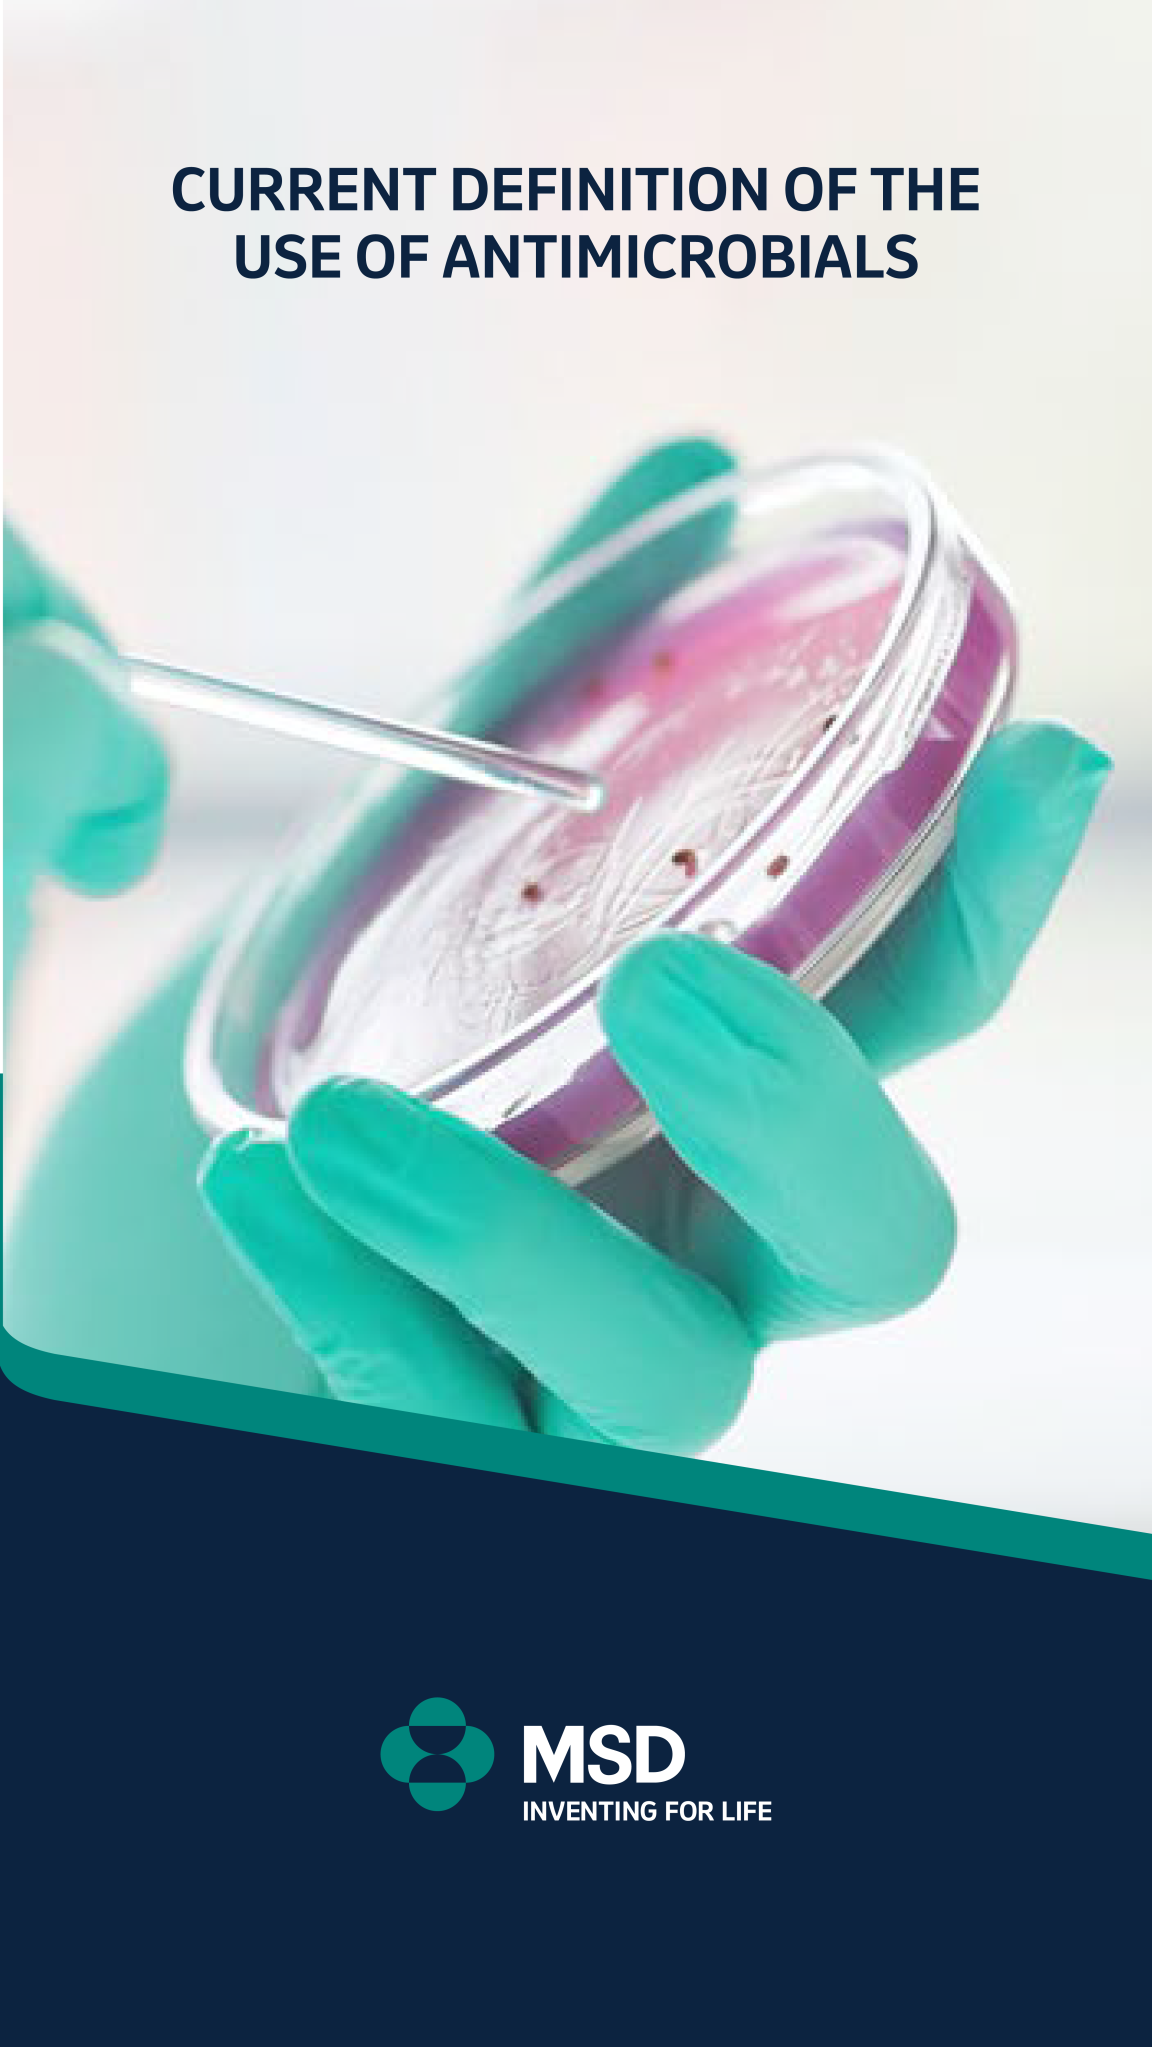

The outpatient parenteral antimicrobial therapy (OPAT)
AN-CAR-00033

AN-CAR-00033

AN-CAR-00037

AN-ECH-00015
AN-CAR-00034

AN-CAR-00035

CD-CAR-00076

N/A

N/A
